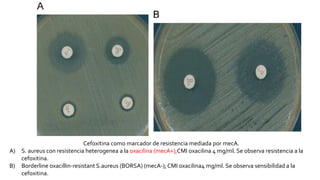
Cefoxitina como marcador de resistencia mediada por mecA.
A) S. aureus con resistencia heterogenea a la oxacilina (mecA+);CMI oxacilina 4 mg/ml. Se observa resistencia a la
cefoxitina.
B) Borderline oxacillin-resistant S.aureus (BORSA) (mecA-); CMI oxacilina4 mg/ml. Se observa sensibilidad a la
cefoxitina.
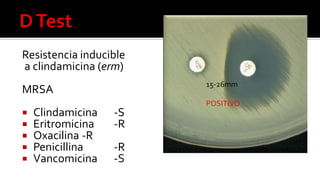
Resistencia inducible
a clindamicina (erm)
MRSA
 Clindamicina -S
 Eritromicina -R
 Oxacilina -R
 Penicillina -R
 Vancomicina -S
15-26mm
POSITIVO
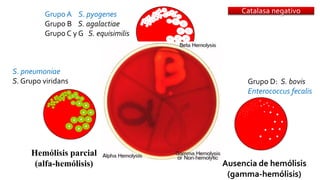
Catalasa negativo
Hemólisis parcial
(alfa-hemólisis)
Hemólisis total
(beta-hemólisis)
Ausencia de hemólisis
(gamma-hemólisis)
S. pneumoniae
S. Grupo viridans
Grupo A S. pyogenes
Grupo B S. agalactiae
Grupo C y G S. equisimilis
Grupo D: S. bovis
Enterococcus fecalis

Este documento describe diferentes mecanismos de resistencia a antibióticos β-lactámicos en bacterias Gram-positivas y Gram-negativas, incluyendo la producción de betalactamasas, la sobreexpresión de proteínas de unión a penicilina, y la adquisición de genes de resistencia. Explica cómo estos mecanismos conducen a perfiles de resistencia específicos y ofrece recomendaciones de tratamiento basadas en los patrones de susceptibilidad.